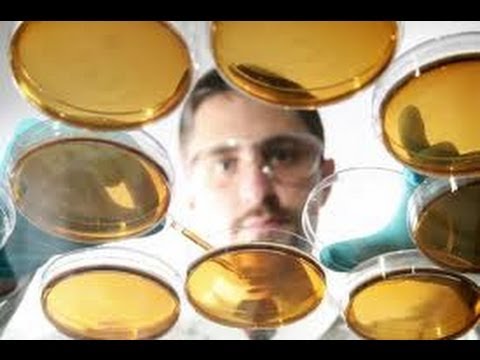
Republican Tries to Bend Science to Anti-Science Agenda

Republican Tries to Bend Science to Anti-Science Agenda
" The new chair of the House of Representatives science committee has drafted a bill that, in effect, would replace peer review at the National Science Found...

The Young Turks
47.9K views • Apr 30, 2013
About this video
" The new chair of the House of Representatives science committee has drafted a bill that, in effect, would replace peer review at the National Science Foundation (NSF) with a set of funding criteria chosen by Congress. For good measure, it would also set in motion a process to determine whether the same criteria should be adopted by every other federal science agency."*
Rep. Lamar Smith - who supported SOPA and blamed gun violence on video games- is continuing the war on science by attempting to remove scientific peer review guidelines and replace it with one determined by Congress...politicizing science. Is this an effort to de-fund science and fund their own corporate propaganda? Cenk Uygur and Ana Kasparian break it down.
*Read more from Science Magazine:
http://news.sciencemag.org/scienceinsider/2013/04/us-lawmaker-proposes-new-criteri-1.html
Support The Young Turks by Subscribing http://www.youtube.com/user/theyoungturks
Like Us on Facebook:
Follow Us on Twitter: http://www.twitter.com/theyoungturks
Support TYT for FREE by doing your Amazon shopping through this link (bookmark it!) http://www.amazon.com/?tag=theyoungturks-20
Buy TYT Merch: http://theyoungturks.spreadshirt.com/
Support The Young Turks by becoming a member of TYT Nation at http://www.tytnetwork.com. Your membership supports the day to day operations and is vital for our continued success and growth. In exchange, we provided members only bonuses! We tape a special Post Game show Mon-Thurs and you get access to the entire live show at your convenience in video, audio and podcast formats.
Rep. Lamar Smith - who supported SOPA and blamed gun violence on video games- is continuing the war on science by attempting to remove scientific peer review guidelines and replace it with one determined by Congress...politicizing science. Is this an effort to de-fund science and fund their own corporate propaganda? Cenk Uygur and Ana Kasparian break it down.
*Read more from Science Magazine:
http://news.sciencemag.org/scienceinsider/2013/04/us-lawmaker-proposes-new-criteri-1.html
Support The Young Turks by Subscribing http://www.youtube.com/user/theyoungturks
Like Us on Facebook:
Follow Us on Twitter: http://www.twitter.com/theyoungturks
Support TYT for FREE by doing your Amazon shopping through this link (bookmark it!) http://www.amazon.com/?tag=theyoungturks-20
Buy TYT Merch: http://theyoungturks.spreadshirt.com/
Support The Young Turks by becoming a member of TYT Nation at http://www.tytnetwork.com. Your membership supports the day to day operations and is vital for our continued success and growth. In exchange, we provided members only bonuses! We tape a special Post Game show Mon-Thurs and you get access to the entire live show at your convenience in video, audio and podcast formats.
Tags and Topics
Browse our collection to discover more content in these categories.
Video Information
Views
47.9K
Likes
2.0K
Duration
7:13
Published
Apr 30, 2013
User Reviews
4.7
(9) Related Trending Topics
LIVE TRENDSRelated trending topics. Click any trend to explore more videos.
Trending Now